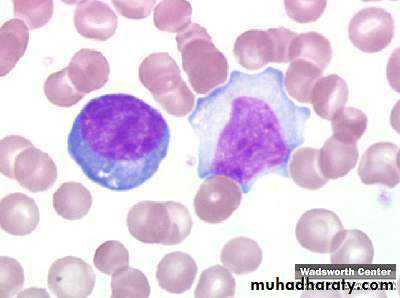

Human Herpesvirus Infections
Dr. Ghazi F. AI- HajiCardiologist
2010
lessonsEpidemiology:.PathogenesisClinical manifestationsDiagnosisPatient managementPrevention
Characteristics of herpes viruses
Persistence
Latency
Reactivation
Tissue tropism
Human Herpes Viruses
AlphaherpesvirusesHSV-1 and HSV-2
Varicella-zoster virus (VZV)
Betaherpesviruses
Cytomegalovirus (CMV)
HHV-6 and HHV-7
Gammaherpesviruses
Epstein-Barr Virus (EBV)
Kaposi’s sarcoma-associated herpesvirus (KSHV,HHV-8)
Cell types infected by different herpesviruses
VZV and HSV• Epithelial cells and neurons
CMV
• Ductal epithelium, leukocytes
EBV
• Oropharyngeal epithelium, B lymphocytes
KSHV
• Endothelium, B cells
Herpes simplex virus
Ubiquitous virus that infects greater than 75% of the adult population (HSV-1) and to varying degrees in the case of HSV-2, depending on the population studied.
There are many manifestations of HSV infection in addition to the common cold sore or fever blister.
Manifestations depend on anatomic site involved, age, immune status of the host
Herpes labialis
Genital herpes
Herpes gladiatorum
Herpetic whitlow
Eczema herpeticum
Congenital HSV infection
Herpetic gingivostomatitis
Disseminated infections
Pneumonia
Esophagitis
Hepatitis
Encephalitis
Chronic and resistant infections
• Infection Type
• Lesions/ Symptoms• Type-specific antibody at time of presentation
• HSV-1
• HSV-2
• First episode, Primary
• (Type 1 or 2)
• +/Severe, bilateral
• -
• -
• First episode, Non-primary
• Type 2
• +/Moderate
• +
• -
• First episode, Recurrence
• Type 2
• +/Mild
• +/-
• +
• Symptomatic, Recurrence
• Type 2
• +/Mild,
• unilateral
• +/-
• +
• Asymptomatic, Infection
• Type 2
• -
• +/-
• +
Oral-Facial Herpes
Gingivostomatitis and pharyngitis most common manifestation of primary HSV−1 infection. in children and young adults and may be subclinical, symptoms and signs include fever, malaise, myalgias, inability to eat, irritability, and cervical adenopathy, may last 3–14 days.Recurrent herpes labialis-reactivation from trigeminal ganglia-lesions
Rx: Acyclovir, Famciclovir, Valacyclovir.
Antivirals-HSVRequire TK phosphorylation for activity
ACV binds to replicating viral DNA causing premature chain termination
ACV and Famciclovir both inhibit viral DNA polymerase
Resistance mediated by reduction in viral TK
Valacyclovir rapidly converted to ACV and higher levels achieved
Excellent activity against HSV
Moderate activity against VZV
Genital Herpes
Primary episode: Fever, headache, myalgias, dysuria, vag/urethral discharge lymphadenopathyLesions: vesicles, pustules, erythematous ulcers
Can be caused by HSV-1 & 2
Recurrence rate higher with HSV-2 infection
HSV proctitis (ulcerative lesions on sigmoidoscopy) and perianal lesions: HIV, rectal intercourse
Trigeminal ganglia & sacral ganglia- most common sites of HSV-1 and HSV-2 latency
Rx: Acyclovir, Famciclovir, Valacyclovir
Neonatal Herpes
Neonates may develop primary HSV infection following vaginal delivery in the presence of active genital HSV infection in the mother. Caesarean section should therefore be considered.< 6weeks of age
Without therapy mortality is approx 65%
Skin lesions most commonly recognized feature - may not appear or may be delayed
Acquired perinatally from contact with genital secretions or close contact with family member
30% due to HSV-1 and 70% HSV-2 ---Rx- IV Acyclovir
Infection of the finger
Occurs as complication of primary oral or genital herpes, direct innoculation, occupational exposureVesicular or pustular lesion
Abrupt onset erythema, localized tendernessFever, lymphadenitis, lymphadenopathy are common
Prompt diagnosisHerpes Gladiatorum
Any skin area may be infected
Transmission facilitated by trauma
Prompt diagnosis to contain the spread
Eczema Herpeticum
Potentially life-threatening viral infection that arises in pre-existing skin conditions like atopic dermatitis
In some cases may lead to fulminant life threatening disseminated infection
Acyclovir, Valacyclovir. Antibiotics may be needed as well
Rare entity
Skin lesions, chorioretinitis, microcephalyH in TORCH infections
Herpes Encephalitis
Accounts for 10-20% of viral encephalitis2.3 cases per 1 million
HSV-1 >95% cases
Biphasic- 5-30, >50yrs
Primary infection or reactivation
Fever, altered mental status, bizarre behavior, seizures
Temporal lobe involved
Diagnosis: LP: Increased CSF protein, leucocytes with lymphocytic predominance and increased CSF RBCs due to hemorrhagic necrosis
CSF HSV PCR: High sensitivity and specificity
Treatment: IV Acyclovir, reduces mortality. Despite treatment mortality upto 15% with survivors with longterm cognitive impairments
Eryrthema Multiforme
EM is a acute self limiting, sometimes recurring skin condition considered to be a Type IV hypersensitivity reaction associated with certain infections, medications.Cell mediated immune reaction associated with HSV antigens
Antigens may be detected in keratinocytes by IF or HSV DNA detected by PCR
Typical “Target Lesions”
Suppression of HSV may prevent EM. Once EM erupts antivirals not effective
“B” virus, Herpesvirus simiae
Endemic HSV homolog of nonhuman primatesRisk for those handling animals
Causes a fulminant neurologic syndrome in humans
May be treatable with acyclovir
Varicella-Zoster Virus Infections
Varicella (Chickenpox)Bacterial superinfection
CNS: aseptic meningitis, transverse myelitis, GBS, encephalitis, Reye’s syndrome
Varicella pneumonia
Myocarditis, nephritis, hepatitis
Perinatal varicella: high mortality
Herpes Zoster (Shingles)
T3-L3 dermatomes most frequently involvedZoster opthalmicus: Opthalmic branch of Trigeminal Nerve involved
Ramsay Hunt syndrome: vesicles , loss of sense of taste in ant 2/3rds of tongue, ipsilateral facial palsy: geniculate ganglia of sensory branch of Facial Nerve involved.
Chickenpox
Childhood diseaseHighly contagious: pt infectious 48hrs prior to rash.
IP: 10-21 days
Fever, malaise, skin lesions: maculopapules, vesicles, pustules, scabs in various stages of evolution
Early lesions “dew drop on rose petal”
Diagnosis: clinical, VZV DNA PCR, Tzanck smear demonstrating multinucleate giant cells, Direct immunofluorescence
Acyclovir therapy efficacious if used <24hrs
Immunocompromised: IV Acyclovir
Chickenpox pulmonary x-ray
Herpes zoster(shingles)
Shingles never occurs as a primary infection but results from reactivation of latent VZV from dorsal root and/or cranial nerve ganglia.It produces skin lesions similar to chickenpox, although classically they are unilateral and restricted to a sensory nerve (dermatomal) distribution.
Shingles occurs at all ages but is most common in the elderly, immune deficiency state or after intra-uterine infection.
The onset of the rash of shingles is usually preceded by severe dermatomal pain (Burning pain), due to involvement of sensory nerves.
complication
The most common and troublesome complication is post-herpetic neuralgia: (persistence of pain for 1-6 months or more following healing of the rash).
Shingles involving the ophthalmic division of the trigeminal nerve can result in blindness in the absence of antiviral therapy.
Herpes Zoster
Opthalmic division of Trigeminal NerveAdapted from: gb.udn.com
HZ: Involvement of tip of nose is classic indicator of ocular involvement (Hutchinson’s sign)Herpes Zoster treatment
Treatment with acyclovir, Famciclovir or valacyclovir is beneficial with accelerated healing of lesions and resolution of neuralgiaImmunocompromised - should receive initial reaction with IV Acyclovir
CMV disease
β Herpes virus dsDNASpread by repeated prolonged exposure
CMV present in breast milk, saliva, feces, urine, semen, cervical secretions
Daycare centers
Once infected person carries CMV for life.
Reactivation syndromes: T cell mediated immunity compromised
Pneumonitis
Bone marrow transplantColitis
AIDS, solid organ transplantation
Retinitis
AIDS
Hepatitis
SOT
Nephritis
Kidney transplantation
Mononucleosis: F/C, malaise, fatigue, splenomegaly, atypical lymphocytosis, leucopenia, LFT abnormalty
Congenital infection: microcephaly, chorioretinitis
When GCV(ganciclovir) enters cells, it must undergo a series of phosphorylations until it is active to be able to inhibit viral DNA polymerase.
The initial phosphorylation step is done by a viral protein kinase that's encoded by UL97.
Mutations in UL97 or in the viral DNA polymerase are the 2 major mechanisms that underlie ganciclovir resistance and antiviral resistance in general
Activity: CMV, HSV, varicella
Adapted from: medscape.com
Cidofovir FoscarnetAnalog of deoxycytidine monophosphate causes premature chain termination of viral DNA and inhibits DNA polymerase
Does not require TK
ACV resistant strains usually not resistant to cidofovir
HSV, CMV, HHV6 & 8, VZV
Nephrotoxic and BM toxicity
Blocks binding of deoxynucleotidyl triphosphate to viral DNA polymerase
CMV, HSV, VZV
CMV retinitis and ACV resistant HSV, GCV resistant CMV
Nephrotoxicity and electrolyte abnormalities
CMV Retinitis
www.kellogg.umich.edu/.../cmv-retinitis.html
Hemorrhages, vessel sheathing, retinal edema
AIDS with CD4<50
IV Ganciclovir then oral Valganciclovir until CD4>100-150
Normal Fundoscopic exam
CMV PneumonitisHighest risk in Lung transplant and BMT patients
High mortality
Diagnosis with BAL(bronchoalveolar lavage) with cells showing viral and inclusions body, PCR. Lung biopsy-gold std
Treatment with IV Ganciclovir
CMV inclusions in lung
http://library.med.utah.edu/WebPath/TUTORIAL/AIDS/AIDS021.htmlCMV colitis
The transplanted organ is particularly vulnerable as a target for CMV infectionPatients may present with diarrhea, heartburn, odynophagia
Diagnosis made with biopsies obtained on endoscopy
CMV immunostain positive
IV Ganciclovir
Thank you for attention
True( T) or false (F)Properties of transforming herpesviruses
• Drive infected cell proliferation• Prevent apoptosis of infected cells
• Avoid immune attack
• Infect new cells
Epstein Barr virus (EBV)-associated diseases
Infectious Mononucleosis
Burkitt lymphoma
Nasopharyngeal carcinomaLymphoproliferative Disease
Hodgkin’s Disease, EBV-assoc. NHL
Gastric carcinoma
Infectious mononucleosis: Kissing disease
Oral Hairy Leukoplakia
White plaques on lateral surface of tongueSeen in HIV/AIDS, immunocompromised individuals
Burkitt’s Lymphoma
Rapidly growing NHL15% of cases in US and 90% cases in Africa associated with EBV
Extremely responsive to chemotherapy and recurrence is rare
from thacher’s.org
Figure 135-4 Nasopharyngeal carcinoma. A, Nests of metastatic undifferentiated nasopharyngeal carcinoma in a fibrous stroma in a lymph node (hematoxylin and eosin). Metastases often lack infiltrating lymphocytes. B, In situ hybridization for Epstein-Barr virus (EBV)-encoded RNA (EBER) (brown) demonstrates EBV infection in most cells in the same area of the tissue. (Magnification ×100.) (Courtesy of Dr. Miguel Rivera.)
Downloaded from: Principles and Practice of Infectious Diseases (on 28 February 2006 03:59 PM)
© 2005 Elsevier
NPC and EBV
Figure 135-3 Mixed cellularity classic Hodgkin's lymphoma. A, Lymph node architecture is effaced by an infiltrate comprised of small lymphocytes, epithelioid histiocytes, plasma cells, eosinophils, and Hodgkin and Reed-Sternberg cells (arrow) (hematoxylin and eosin). B, In situ hybridization for Epstein-Barr virus (EBV)-encoded RNA (EBER) (brown) demonstrates EBV infection in the malignant Hodgkin and Reed-Sternberg cells. (Original magnification x400.) (Courtesy of Dr. Jeffery Kutok.)
Downloaded from: Principles and Practice of Infectious Diseases (on 28 February 2006 04:00 PM)
© 2005 Elsevier
Hodgkin’s lymphoma and EBV
Figure 135-2 Post-transplantation lymphoproliferative disease involving the colon. A, The tumor is composed of large, atypical lymphoid cells (hematoxylin and eosin). Scattered macrophages (arrow) are seen, producing a "starry-sky" appearance. B, In situ hybridization for Epstein-Barr virus (EBV)-encoded RNA (EBER) (brown) shows variably intense nuclear staining in the majority of tumor cells, indicating EBV infection. (Original magnification x400.) (Courtesy of Dr. Jeffery Kutok.)
Downloaded from: Principles and Practice of Infectious Diseases (on 28 February 2006 04:00 PM)
© 2005 Elsevier
PTLD and EBV
Kaposi’s sarcoma-associated virus (KSHV, HHV8)
Kaposi’s sarcoma (KS)Multicentric Castleman’s disease
Primary Effusion Lymphoma (PEL)
Kaposi’s sarcoma
Classic Kaposi's sarcoma (CKS) is a neoplasm characterized by abnormal angiogenesis that requires infection with a human herpes virus, HHV-8, along with other cofactors.purplish, reddish blue, or dark brown/black macules, plaques, and nodules on the skin.
mucous membranes of mouth and gastrointestinal (GI) tract and regional lymph nodes may be affected later in the course.
Biopsy for definitive diagnosis
radiation therapy, excision, cryotherapy, laser ablation, chemotherapy
emedicine.medscape.com/article/279734-overview
Figure 137-2 Kaposi's Sarcoma Involving a Lymph Node. Left panel, Spindle cell proliferation (white arrows) containing poorly formed vascular spaces with entrapped red blood cells (black arrows). Areas of uninvolved lymph node (LN) are seen at the top (H&E). Right panel, Immunohistochemical detection of Kaposi's sarcoma-associated human herpesvirus (KSHV) latency-associated nuclear antigen 1 (LANA1) (brown) in the nuclei of many spindle cells indicates KSHV infection (×200). (Courtesy of Dan Jones, MD, PhD.)
Downloaded from: Principles and Practice of Infectious Diseases (on 28 February 2006 03:59 PM)
© 2005 Elsevier
Kaposi’s sarcoma: Seen in AIDS patients
Fever, LAN, hepatosplenomegaly, night sweats
Most patients with MCD die due to fulminant infection, progressive disease or related malignancyHuman Herpes Viruses
AlphaherpesvirusesHSV-1 and HSV-2
Varicella-zoster virus (VZV)
Betaherpesviruses
Cytomegalovirus (CMV)
HHV-6 and HHV-7
Gammaherpesviruses
Epstein-Barr Virus (EBV)
Kaposi’s sarcoma-associated herpesvirus (KSHV,HHV-8)
Cell types infected by different herpesviruses
VZV and HSV
• Epithelial cells and neurons
CMV
• Ductal epithelium, leukocytes
EBV
• Oropharyngeal epithelium, B lymphocytes
KSHV
• Endothelium, B cells
Take Home points
Latency and potential for reactivationImmunocompromised with defective cell mediated immunity at risk of severe disease
HSV- Acyclovir
HSV encephalitis: IV ACV improves mortality
Chickenpox: lesions in various stages of development
Zoster Opthalmicus: opthalmic division of Trigeminal Nerve
VZV diagnosis: Tzanck smear- mulinucleate giant cells, PCR
CMV : Mononucleosis without exudative pharyngitis
CMV retinitis, colitis, pneumonia
CMV dx: PCR, cells with classic inclusions on biopsy
EBV: IM, Heterophile antibody positive
Transforming virus: EBV, KSHV, HHV-8